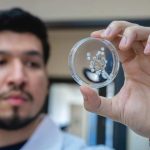
Investigadores crean hidrogel a base de veneno de avispa que cura lesiones de pie diabético Investigadores crean hidrogel a base de veneno de avispa que cura lesiones de pie diabético

¿Tu hijo enfrenta desafíos de salud que dificultan su educación tradicional? colegio en línea Atesora School ofrece un entorno de aprendizaje seguro y flexible, diseñado para adaptarse a las necesidades individuales de cada estudiante. Con su programa online, tu hijo podrá continuar aprendiendo y creciendo sin comprometer su bienestar.
Colegio en línea para estudiantes con necesidades especiales y problemas de salud
En la era digital, la educación también se ha transformado para adaptarse a las necesidades y estilos de aprendizaje de los estudiantes. Atesora School es un colegio en línea que ofrece una educación de calidad desde quinto básico hasta cuarto medio, con una preparación especial para el PAES (Prueba de Acceso a la Educación Superior) y una variedad de talleres para complementar la formación académica.
Una de las principales ventajas de Atesora School es su flexibilidad. Los estudiantes pueden acceder a los cursos y materiales en línea desde cualquier lugar y en cualquier momento, lo que les permite organizar su tiempo de estudio de acuerdo a sus necesidades y ritmo de aprendizaje.
«La flexibilidad es fundamental para nosotros», explica la directora de Atesora School. «Sabemos que cada estudiante es único y tiene sus propias necesidades y estilos de aprendizaje. Nuestra plataforma en línea permite a los estudiantes aprender a su propio ritmo y en su propio tiempo». Nos comenta Raquel Villarroel, sostenedora de Atesora School.
Colegio en línea ATESORA Home School
Otra ventaja importante de Atesora School es su enfoque en la preparación para el PAES. Los estudiantes que cursan en Atesora School tienen acceso a materiales y recursos especializados para prepararse para la prueba, lo que les da una ventaja competitiva en el proceso de admisión a la educación superior.
«La preparación para el PAES es fundamental para los estudiantes que buscan ingresar a la educación superior», explica la directora. «Nuestra plataforma en línea ofrece recursos y materiales especializados para ayudar a los estudiantes a prepararse para la prueba y aumentar sus posibilidades de éxito».
Además de la preparación para el PAES, Atesora School también ofrece una variedad de talleres para complementar la formación académica de los estudiantes. Los talleres están diseñados para ayudar a los estudiantes a desarrollar habilidades y competencias específicas en áreas como la tecnología, la creatividad y la comunicación.
«Los talleres son una forma excelente de complementar la formación académica de los estudiantes», explica la directora. «Nuestros talleres están diseñados para ayudar a los estudiantes a desarrollar habilidades y competencias específicas que les serán útiles en su futuro académico y profesional».
En resumen, Atesora School es un colegio en línea que ofrece una educación de calidad desde quinto básico hasta cuarto medio, con una preparación especial para el PAES y una variedad de talleres para complementar la formación académica. La flexibilidad y la accesibilidad de la plataforma en línea hacen que Atesora School sea una excelente opción para los estudiantes que buscan una educación de calidad y flexible.
Matriculas disponibles en www.atesoraschool.cl